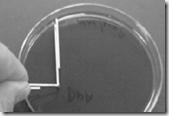

Mikrobiologi adalah suatu ilmu yang mempelajari kehidupan makhluk yang bersifat mikroskopik yang disebut mikroorganisme atau jasad renik, yaitu makhluk yang mempunyai ukuran sel sangat kecil dimana setiap selnya hanya dapat dilihat dengan pertolongan mikroskop. Dalam teknologi pangan, mikrobiologi merupakan ilmu yang sangat penting, misalnya dalam hubungannya dengan kerusakan atau kebusukan makanan sehingga dapat diketahui tindakan pencegahan atau pengawetan yang paling tepat untuk menghindari terjadinya kerusakan tersebut. Di samping itu, mikrobiologi juga penting dalam fermentasi makanan, sanitasi, pengawasan mutu pangan, dan sebagainya. Adanya jasad renik di dalam makanan mungkin tidak diinginkan jika jasad renik tersebut dapat menyebabkan kerusakan dan kebusukan makanan, atau menyebabkan keracunan bagi yang mengkonsumsinya. Tetapi dalam fermentasi makanan dan minuman, pertumbuhan jasad renik justru dirangsang untuk mengubah komponen-komponen di dalam bahan pangan tersebut menjadi produk-produk yang diinginkan (4, hal 3).
Di dalam pekerjaan mikrobiologi seringkali kita tidak terlepas dari alat-alat yang berada dalam laboratorium. Untuk itu diperlukan pemahaman tentang fungsi dan sifat-sifat dari alat yang digunakan. Peralatan yang digunakan pada laboratorium mikrobiologi hampir sama dengan peralatan-peralatan yang umumnya digunakan di laboratorium kimia yaitu berupa alat-alat gelas antara lain : tabung reaksi, cawan petri, pipet ukur dan pipet volumetrik, labu ukur (tentukur), labu erlenmeyer, gelas piala, pH meter, gelas arloji, termometer, botol tetes, pembakar spiritus, kaki tiga dengan kawat asbes dan rak tabung.
Di samping peralatan gelas tersebut pada laboratorium mikrobiologi masih ada sejumlah alat yang khusus antara lain: otoklaf, oven, mikroskop, jarum ose (inokulasi), jarum preparat, gelas objek, kaca penutup, keranjang kawat untuk sterilisasi, inkubator untuk membiakkan mikroorganisme dengan suhu yang konstan, spektrofotometer untuk mengukur kepekatan suspensi atau larutan. Penangas air untuk mencairkan medium, maknetik stirrer untuk mengaduk dan tabung durham untuk penelitian fermentasi.
Di dalam pekerjaan mikrobiologi dibutuhkan alat yang khusus untuk melihat mikroorganisme. Salah satu alat yang sering digunakan adalah mikroskop. Mikroskop merupakan alat bantu yang memungkinkan kita dapat mengamati objek yang berukuran kecil. Mikroskop dalam bahasa Yunani dari micron yaitu kecil dan scopos yaitu tujuan. Jadi, mikroskop adalah sebuah alat untuk melihat objek yang terlalu kecil. Ilmu yang mempelajari benda kecil dengan menggunakan alat ini disebut mikroskopi, dan kata mikroskopik berarti sangat kecil, tidak mudah terlihat oleh mata. Daya pembesaran mikroskop menyebabkan kita dapat melihat struktur mikroorganisme yang tidak dapat terlihat dengan mata telanjang. Pembesaran yang dapat mikroskop adalah sekitar 100 kali sampai 400.000 kali. Ada dua jenis mikroskop berdasarkan pada kenampakan objek yang diamati, yaitu mikroskop dua dimensi (mikroskop cahaya) dan mikroskop tiga dimensi (mikroskop stereo). Sedangkan berdasarkan sumber cahayanya, mikroskop dibedakan menjadi mikroskop cahaya dan mikroskop electron (3).
Berdasarkan konstruksi dan kegunaan, maka mikroskop cahaya dibagi menjadi biological microscope(mikroskop biologis) dan stereo microscope (mikroskop stereo). Berdasarkan cahaya yang melewati mikroskop maka mikroskop cahaya dibagi menjadi mikroskop stereo, mikroskop medan terang, mikroskop fourensensi, mikroskop fase kontras, mikroskop interferensi, mikroskop polarisasi, dan mikroskop ultraviolet (1, hal121).
Perbesaran yang dicapai oleh suatu mikroskop adalah hasil kerja dua sistem lensa yaitu lensa objektif dan lensa okuler. Lensa objektif yang terdekat dengan spesimen, dan lensa okuler, terletak pada ujung atas mikroskop, terdekat dengan mata. Sistem lensa objektif memberikan perbesaran mula-mula dan menghasilkan bayangan nyata yang kemudian diproyeksikan ke atas lensa okuler. Bayangan nyata tersebut, pada gilirannya, diperbesar oleh okuler untuk menghasilkan bayangan pada mikroskop (2, hal 6).
Pada mikroskop cahaya atau mikroskop monokuler mempunyai perbesaran maksimum 1000 kali. Mikroskop ini mempunyai kaki yang berat dan kokoh dengan tujuan agar dapat berdiri dengan stabil. Mikroskop cahaya memiliki tiga sistem lensa yaitu lensa objektif, lensa okuler, dan kondensor. Lensa okuler bisa berbentuk lensa tunggal (monokuler) atau ganda (binokuler). Pada ujung bawah mikroskop terdapat tempat dudukan lensa objektif yang bisa dipasangi tiga lensa atau lebih. Di bawah tabung mikroskop terdapat meja mikroskop yang merupakan tempat preparat. Sistem lensa yang ketiga adalah kondensor. Kondensor berperan untuk menerangi objek dan lensa-lensa mikroskop yang lain (3).
Kondensor adalah sistem lensa pengumpul cahaya di bawah pentas yang memusatkan cahaya yang tersedia pada spesimen. Kondensor dapat digerakkan ke atas dan ke bawah oleh pengatur kondensor. Kondensor berfungsi untuk mendukung terciptanya pencahayaan pada objek yang akan difokus, sehingga bila pengaturannya tepat akan diperolehdaya pisah maksimal. Jika daya pisah kurang maksimal, dua benda akan tampak menjadi satu. Perbesaran akan kurang bermanfaat jika daya pisah mikroskop kurang baik (2, hal 9).
Pada pengerjaan mikrobiologi, diperlukan suatu kondisi yang benar-benar aseptik dimana alat penunjang serta nutrient dan substrat harus benar-benar steril. Hal ini berarti mikroba kontaminan harus dimatikan. Sterilisasi dilakukan pada suhu 121 oC selama 30 menit, yaitu agar spora atau mikroba dapat dimatikan. Spora adalah sel istirahat yang resisitan terhadap panas dan lingkungan yang berfungsi sebagai tunas untuk berkembang biak selanjutnya. Udara tekan yang digunakan juga harus dalam kondisi steril. Substrat yang berisi nutrien tidak peka terhadap suhu, maka sterilisasi media substrat dilakukan pada 138 oC selama 5 menit. Pada substrat yang berisi nutrien tetapi peka terhadap suhu, maka sterilisasi media substrat dilakukan dengan penyaringan bertekanan melalui saringan milipore diameter 0,22 µm (5, hal 11).
Yang dimaksud sterilisasi dalam mikrobiologi adalah suatu proses untuk mematikan semua organisme yang terdapat pada atau di dalam suatu benda. Ketika untuk pertama kalinya melakukan pemindahan biakan bakteri secara aseptic, sesungguhnya hal itu telah menggunakan salah satu cara sterilisasi, yaitu pembakaran. Namun, kebanyakan peralatan dan media yang umum dipakai di dalam pekerjaan mikrobiologi akan menjadi rusak bila dibakar. Untungnya tersedia berbagai metode lain yang efektif (2, hal 55).
Sterilisasi diperlakukan pada :
1. Sterilisasi produk pangan dalam kaleng, botol, dan kemasan lain.
2. Sterilisasi media cair dan nutrien untuk industry bioteknologimisalnya, obat-obatan dan enzim.
3. Sterilisasi bioreaktor dengan alat pengendali dan pemonitor.
(5, hal 194)
Jenis-jenis sterilisasi berdasarkan cara sterilisasi dapat dibedakan atas:
1. Sterilisasi secara fisik
2. Sterilisasi secara kimia
3. Sterilisasi secara mekanik
4. Sterilisasi secara gas mikroksidal
5. Sterilisasi dengan saringan membrane
(5, hal 195)
Ada tiga cara utama yang umum dipakai dalam sterilisasi yaitu penggunaan panas, bahan kimia, dan penyaringan (filtrasi). Bila panas digunakan bersama-sama dengan uap air maka disebut sterilisasi panas lembab atau sterilisasi basah, bila tanpa kelembaban maka disebut sterilisasi panas kering atau sterilisasi panas kering. Di pihak lain, sterilisasi kimiawi dapat dilakukan dengan menggunakan gas atau radiasi. Pemilihan metode didasarkan pada sifat bahan yang akan disterilkan. Metode sterilisasi yang umum digunakan secara rutin di laboratorium mikrobiologi adalah yang menggunakan panas (2, hal 55).
Sterilisasi basah biasanya dilakukan di dalam autoklaf atau sterilisator uap yang mudah diangkat (portable) dengan menggunkan uap air jenuh bertekanan pada suhu 121 oC selama 15 menit. Karena titik didih air menjadi 121 oC itu disebabkan oleh tekanan 1 atmosfer pada ketinggian permukaan laut, maka daur sterilisasi tersebut seringkali juga dinyatakan sebagai : 1 atm 15 menit. Pada tempat-tempat yang lebih tingginya diperlukan tekanan lebih besar untuk mencapai suhu 121 oC. Karena itu daripada menyatakan besarnya tekanan, lebih baik menyatakan bahwa keadaan steril dicapai dengan cara mempertahankan suhu 121 oC selama 15 menit (2, hal 55).
Sterilisasi basah dapat digunakan untuk mensterilkan bahan apa saja yang dapat ditembus uap air dan tidak rusak bila dipanaskan dengan suhu yang berkisar antara 110 oC dan 121 oC. Bahan-bahan yang biasa disterilkan dengan cara ini antara lain medium biakan yang umum, air suling,peralatan laboratorium, biakan yang akan dibuang, medium tercemar, dan bahan-bahan dari karet(2, hal 56).
Ada 4 hal utama yang harus diingat bila melakukan sterilisasi basah ;
1. Sterilisasi bergantung pada uap, karena itu udara harus dikosongkan betul-betul dari ruang sterilisator.
2. Semua bagian bahan yang disterilkan harus terkenai uap, karena itu tabung dan labu kosonga harus diletakkan dalam posisi tidur agar udara tidak terperangkap di dasarnya.
3. Bahan-bahan yang berpori atau berbentuk cair harus permeabel terhadap uap.
4. Suhu sebagaimana yang terukur oleh thermometer harus mencapai 121 oC dan dipertahankan stinggi itu 15 menit.
(2, hal 56)
Sterilisasi panas kering dapat diterapkan pada apa saja yang tidak merusak, menyala, hangus, dan menguap pada suhu setinggi itu. Bahan-bahan yang biasa disterilkan dengan cara ini antara lain pecah belah seperti pipet, tabung reaksi, cawan petri dari kaca, botol sampel, juga peralatan seperti jarum suntik, dan bahan-bahan yang tidak tembus uap seperti gliserin, minyak, vaselin, dan bahan-bahan berupa bubuk. Bahan-bahan yang disterilkan harus dilindungi dengan cara membungkus, menyumbat atau menaruhnya dalam suatu wadah tertutup untuk mencegah kontaminasi setelah dikeluarkan dari oven (2, hal 57).
Proses sterilisasi lain yang juga dilakukan pada suhu kamar ialah penyaringan. Dengan cara ini larutan atau suspensi dibebaskan dari semua organisme hidup dengan cara melakukannya lewat saringan dengan ukuran pori yang sedemikian kecilnya sehingga bakteri dan sel-sel yang lebih besar tertahan di atasnya, sedangkan filtratnya ditampung di dalam wadah yang steril. Beberapa contoh bahan yang biasa disterilkan dengan cara ini ialah serum, larutan bikarbonat, enzim, toksin bakteri, medium sintetik tertentu, dan antibiotik (2, hal 58).
BAB III
METODE KERJA
Cara Kerja
Mengamati alat-alat yang akan digunakan dalam laboratorium mikrobiologi, serta dapat memahami prinsip kerja dan fungsi dari masing-masing alat, dan dapat menggambar masing-masing alat yang digunakan.
BAB V
PEMBAHASAN
1. Alat-alat Sterilisasi
Alat-alat sterilisasi meliputi Otoclaf, Oven, Ozonsterilizer, dan Lampu Spritus. Oven merupakan alat sterilisasi dengan menggunakan udara panas kering, dimana oven berfungsi mensterilisasi alat-alat gelas yang tidak bersekala. Perinsip dari oven ini sendiri adalah menghancurkan lisis mikroba menggunakan udara panas kering.
Ozonsterilizer berfungsi mensterilisasikan alat-alat yang tidak bersekala. Ozonsterilizer terdiri atas dua bagian, yakni bagian atas dan bagian bawah. Bagian atas ozonsterilizer mempunyai prinsip kerja membunuh mikroba menggunakan ozon (O3), dimana ozon dapat merusak mekanisme dari mikroba sehingga sel protein pada mikroba mengalami oksidasi yang mengakibatkan perubahan fungsi dan kematian pada mikroba, dan ozon (O3) itu sendiri bersifat racun. Bagian bawah dari ozonsterilizer (elektra) berfungsi mensterilisasikan medium menggunakan sinar lampu dengan panas tinggi, dimana cara kerjanya hampir sama dengan oven.
Otoclaf berfungsi mensterilisasikan alat-alat bersekala menggunakan uap air panas. Dimana uap air panas akan merusak protein mikroba hingga mengalami koogulasi, pada saat itu protein akan mengendap (denaturasi) dan menyebabkan kematian pada mikroba. Saat penggunaan otoclaf penutupan harus benar-benar rapat agar uap air yang bertekanan tinggi masuk kedalam atau beruduksi ke alat.
Lampu spritus merupakan alat yang digunakan untuk pemijaran serta untuk mensterilisasikan mikroba. Lampu spritus juga mempunyai fungsi lain, yakni mengamankan praktikan pada saat melakukan penanaman medium.
2. Alat-alat perhitungan koloni mikroorganisme.
Alat-alat yang tergolong dari alat perhitungan koloni adalah coloni counter dan cawan petri. Coloni counter merupakan alat yang berfungsi sebagai penghitung jumlah mikroba pada cawan petri menggunakan sinar dan luv. Perhitungan mikroba dapat dilakukan dengan perbesaran menggunakan luv atau dengan menandai beberapa koloni yang terdapat pada cawan petri menggunakan bulpoint yang terdapat pada coloni counter dan juga menggunakan tombol check.
Cawan petri berfungsi sebagai tempat pertumbuhan mikroba secara kuantitatif dan sebagai tempat pengujian sampel.
3. Alat lainnya
Mikroskop berfungsi sebagai alat bantu untuk melihat mikroorganisme yang tak dapat dilihat oleh mata. Cara penggunaan mikroskop adalah dengan membelakangi bagian belakang mikroskop. Mikroskop yang digunakan antara lain elektron, mikroskop cahaya, dan mikroskop kemera. Mikroskop cahaya (Monokoler) berfungsi untuk melihat objek dengan bantuan cahaya. Mikroskop ini digunakan dengan satu mata, sehingga bayangan yang terlihat hanya memilki panjang dan lebar, dan memberikan gambaran mengenai tingginya. Prinsip kerja dari mikroskop ini adalah dengan memantulkan cahaya melalui cermin, lalu diteruskan hingga lensa objektif. Di lensa objektif bayangan yang dihasilkan adalah maya, terbalik dan diperbesar. Kemudian bayangan akan diteruskan dan menghasilkan bayangan tegak, nyata dan diperbesar oleh mata pengamat. Semakin banyak cahaya yang dipantulkan melalui cermin, maka akan semakin terang pula mikroorganisme yang dilihat. Mikroskop ini memiliki pembasaran objektif (10x dan 40x) serta pembesaran okuler (10x). Mikroskop elektron (Biokuler) berfungsi untuk melihat objek dengan bantuan elektron atau cahaya lampu. terdiri atas empat lensa objektif dengan empat pembesaran, 10x, 25x, 40x dan 100x. Saat pengunaan menggunakan pembesaran 100x, ditambahkanminyak emersi di atas gelas objek. Tujuannya adalah untuk mengurangi sudut bias akibat banyaknya cahaya yang dipantulkan. Tanpa minyak emersi, maka objek yang akan diteliti, tidak akan terllihat. Mikroskop ini digunakan saat melihat struktur dan melakukan pewarnaan bakteri. Mikroskop kamera (Triokuler) berfungsi sebagai pengambil gambar (objek). Lensa okuler yang terdapat dalam mikroskop ini sejumlah tiga lensa okuler. Mikroskop ini dapat mengambil gambar dari preparat. Maka dari itu, mikroskop ini hanya akan digunakan bila ingin mengambil gambar objek yang akan diamati. Prinsip kerjanya sama seperti mikroskop cahaya, hanya ada sedikit perbedaan dalam mengoperasikannya.
Centrifuge merupakan alat yang berfungsi sebagai pemisah zat dalam cairan yang diduga dapat mengendap dengan cara pemutaran menggunakan kekuatan rotasi. Dengan pemutaran kecepatan tertentu, zat-zat yang tidak terlarut akan mengendap. Satuaan yang digunakan pada centrifuge adalah Rpm (Rotation per meter). Perinsip kerja dari alat ini adalah zat yang akan dipisahkan dimasukkan kedalam tabung yang terdapat pada centrifuge, kemudian menutup lubang pada centrifuge agar udar yang masuk tidak mempengaruhi zat yang akan dipisah. Setelah itu tentukan waktu dan rotasi putaran yang diinginkan, dengan memutar tombol Timer dan Rotation.
Sepektrometri adalah alat yang berfungsi untuk mengukur kepekatan dalam larutan menggunakan cahaya. Prinsip kerja alat ini adalah membiaskan cahaya kedalam kupet yang berisi sampel (zat), sebagian sinar akan ada yang diteruskan dan sebagian lagi akan diserap. Saat pemasangan kupet ke dalam sepektometri tidak boleh menggunakan tangan, karena minyak yang terdapat pada tangan akan menempel pada kupet dan mempengaruhi hasil akhirnya.
Pipet volume adalah alat yang berfungsi sebagai pengambil larutan atau sampel sesuai dengan jumlah yang kita tentukan. Pipet gondok berfungsi sama seperti pipet volum, hanya saja pengambilan larutan sudah ditentukan. Cara sterilisasinya menggunakan otoklaf.
Lumpang dan Alu berfungsi sebagai tempat menggerus bahan yang akan diuji, disterilisasi dengan cara dimasukkan alkohol 70%, lalu dimasukkan api sampai padam.Objek gelas digunakan dalam meneliti kapang dan cover glassberfungsi melindungi sampel.
Tabung reaksi berfungsi sebagai tempat media pertumbuhan mikroba alam bentuk media tegak atau miring yang disumbat dengan kapas, dibulatkan lalu disterilkan dengan kapas berada tetap di atasnya dan diikat, sedangkan rak tabung sebagai tempat untuk meletakkan tabung reaksi.
Tabung Durham berfungsi untuk menangkap gas O2 yang dihasilkan dari hasil fermentasi mikroorganisme biasa digunakan dalam medium cair. Cara sterilisasinya menggunakan alat otoklaf.
Ose berfungsi untuk mengambil dan menggores MO, terdiri dari ose lurus untuk menanam MO dan ose bulat untuk menggores MO yang biasanya berbentuk zig-zag.
Paper Disk merupakan alat yang terbuat dari kertas saring dan dicelupkan ke dalam cairan antibiotik, disterilisasi dengan oven.
Pinset berfungsi untuk menjepit atau mengambil pencadang, sterilisasinya dapat dilakukan dengan dibakar menggunakan lampu spiritus. Sedangkan pencadang berfungsi untuk melihat daerah hambatan atau zona halo yang diisi dengan antibiotik. Ukurannya yaitu diameter luar = 8 mm, diameter dalam = 6 mm, panjang = 10 mm. Pencadang disterilisasi dengan dimasukkan ke dalam cawan petri lalu dimasukkan ke dalam oven.
Timbangan Analitik berfungsi untuk menimbang bahan kimia. Timbangan ini memiliki batas maksimal penimbangan. Jika melewati batas tersebut, maka ketelitian perhitungan akan berkurang.
Tabung reaksi berfungsi sebagai tempat untuk melarutkan bahan, menampung larutan, dan tempat untuk mencampurkan bahan lalu dimasukkan ke dalam labu Erlenmeyer. Alat ini dapat disterilisasikan dengan dibungkus terlebih dahulu dengan kertas saring bagian atasnya lalu dibungkus dengan kertas dan diikat, lalu dimasukkan ke dalam otoklaf.
Labu erlenmeyer berfungsi sebagai tempat penyimpanan medium, memanaskan larutan, dan menampung hasil dari penyaringan. Alat ini dapat disterilisasikan dengan ditutup terlebih dahulu bagian atas dengan kapas, lalu disterilisasi dengan menggunakan otoklaf.
Neraca Ohauss 311 merupakan alat yang digunakan untuk menimbang medium. Pada saat dilakukan penimbangan, digunakan kertas timbang.
Spoid berfungsi untuk mengambil larutan, zat hasil pengukuran, atau zat yang mau diuji. Alat ini dapat disterilisasikan dengan menggunakan otoklaf (uap air bertekanan) dimana sebelum disterilisai dibungkus terlebih dahulu.
Mikrometer skrup berfungsi untuk mengukur tebal dan tipis (diameter) atau luas daerah anti bakteri. Alat ini memiliki dua skala, sehingga memiliki tingkat ketelitian yang lebih tinggi dan tidak perlu disterilisasikan.
BAB VI
PENUTUP
I. Kesimpulan
Alat-alat Sterilisasi : Ozontsterilizer, Oven, Otoclaf, Lampu spiritus, Alat-alat Perhitungan Koloni Mikroorganisme, Coloni counter.
Alat-alat lainnya : Centrifu, Gelas ukur, Gelas kimia, Labu ukur, Labu erlenmeyer, Lumpan dan alu, Neraca ohauss, Pipet volume, Pipet gondok, Mikropipet, Mukrometr skrub, Pinset, Spoid, Glass objek, Cover glass, Inkubator, Kulkas, Tabung reaksi,Tabung durham, Ose lurus, Ose bulat, Peperdisk.
Timbangan analitik : Spektrofotometri, Pencadang, Mikroskop cahaya, Mikroskop elektron, Mikroskop kamera
II.Saran
Alat yang akan digunakan terlebih dahulu harus disterilisasikan atau benar-benar steril. Praktikan sudah dapat mengetahui pengelompokkan alat-alat yang akan distrilisasi dan cara mensterilisasi, seperti perlakuan khusus pada alat-alat berskala maupun lainnya. Saat memegang alat sebaiknya praktikan menggunakan handspon, agar dipastikan alat benar-benar steril.
DAFTAR PUSTAKA
1. Gabriel, J.F., 1988, Fisika Kedokteran, EGC; Jakarta, hal.
2. Hadioetomo, Ratna Siri, 1993, Mikrobiologi Dasar dalam Praktek, Gramedia
Pustaka Utama; Jakarta, hal. 6, 9, 55-58.
3. Http://bima.ipb.ac.id/
4. Kardiaz, Srikandi, 1992, Mikrobiologi Pangan I, Gramedia; Jakarta, hal. 3.
5. Suharto, Ign., 1995, Bioteknologi dalam Dunia Industri, Andi Offset;
http://farmasiq.blogspot.com/ arie,2008
Pengenalan alat-alat laboratorium penting dilakukan untuk keselamatan kerja saat melakukan penelitian. Alat-alat laboratorium biasanya dapat rusak atau bahkan berbahaya jika penggunaannya tidak sesuai dengan prosedur (Plummer, 1987). Pentingnya dilakukan pengenalan alat-alat laboratorium adalah agar dapat diketahui cara penggunaan alat tersebut dengan baik dan benar, sehingga kesalahan prosedur pemakaian alat dapat diminimalisasi sedikit mungkin. Hal ini penting supaya saat melakukan penelitian, data yang diperoleh akan benar pula. Data-data yang tepat akan meningkatkan kualitas penelitian seseorang. Selain itu, bahan dan peralatan yang digunakan dalam penelitian harus dalam kondisi steril. Untuk mencapainya, maka diperlukan teknik sterilisasi. Sterilisasi ialah proses-proses untuk menjadikan peralatan dan bahan-bahan bebas dari semua bentuk kehidupan. Tujuan utamanya adalah supaya sebelum pengkulturan dapat mematikan mikroorganisme yang tidak diinginkan dan tidak turut tumbuh dalam kultur murni (suatu kultur mikroorganisme yang tersusun dari sel-sel sejenis). Teknik Sterilisasi dibedakan menjadi empat kelompok, antara lain : Sterilisasi fisik dengan panas, sterilisasi mekanik dengan filter, sterilisasi kimia, dan sterilisasi radiasi.
Pada dasarnya setiap alat memiliki nama yang menunjukkan kegunaan alat, prinsip kerja atau proses yang berlangsung ketika alat digunakan. Beberapa kegunaan alat dapat dikenali berdasarkan namanya.Penamaan alat-alat yang berfungsi mengukur biasanya diakhiri dengan kata meter seperti thermometer,hygrometer dan spektrofotometer,dll. Alat-alat pengukur yang disertai dengan informasi tertulis, biasanya diberi tambahan “graph” seperti thermograph,barograph ( Moningka, 2008).
Dari uraian tersebut,tersirat bahwa nama pada setiap alat menggambarkan mengenai kegunaan alat dan atau menggambarkan prinsip kerja pada alat yang bersangkutan. Dalam penggunaannya ada alat-alat yang bersifat umum dan ada pula yang khusus. Peralatan umum biasanya digunakan untuk suatu kegiatan reparasi, sedangkan peralatan khusus lebih banyak digunakan untuk suatu pengukuran atau penentuan (Moningka,2008).
Antonie Van Leuwenhook adalah orang yang pertama kali melihat bakteri dengan menggunakan instrumen optik yang terdiri atas lensa bikonvens. Pada waktu itu ia menemukan bakteri dalam berbagai cairan, diantara cairan tubuh, air, ekstrak lada, serta bir. Penemuan mikroskop pada waktu itu membuka peluang unttuk dilakukannya penelitian mengenai proses terjadinya fermentasi dan penemuan jasad renik penyebab penyakit (Ferdias, 1992).
Mikroskop adalah alat yang paling khas dalam laboratorium mikrobiologi yang memberikan perbesaran yang membuat kita dapat melihat struktur mikroorganisme yang tidak dapat dilihat oleh mata telanjang. Mikroskop yang tersedia menungkinkan jangkauan perbesaran yang luas dari beberapa kali hingga ribuan kali (Lay,1994).
Adapun alat-alat yang dipergunakan pada laboratorium mikrobiologi antara lain (Blacksweetranger,2008) :
• Mikroskop Cahaya (Brightfield Microscope)
Salah satu alat untuk melihat sel mikroorganisme adalah mikroskop cahaya. Dengan mikroskop kita dapat mengamati sel bakteri yang tidak dapat dilihat dengan mata telanjang. Pada umumnya mata tidak mampu membedakan benda dengan diameter lebih kecil dari 0,1 mm. berikut merupakan uraian tentang cara penggunaan bagian-bagiandan spesifikasi mikroskop cahaya merk Olympus CH20 yang dimiliki Laboratorium Mikrobiologi.
• Autoklaf
Autoklaf adalah alat untuk mensterilkan berbagai macam alat dan bahan yang digunakan dalam mikrobiologi menggunakan uap air panas bertekanan. Tekanan yang digunakan pada umumnya 15 Psi atau sekitar 2 atm dan dengan suhu 121oC (250oF). Jadi tekanan yang bekerja ke seluruh permukaan benda adalah 15 pon tiap inchi2 (15 Psi = 15 pounds per square inch). Lama sterilisasi yang dilakukan biasanya 15 menit untuk 121oC.
• Inkubator (Incubator)
Inkubator adalah alat untuk menginkubasi atau memeram mikroba pada suhu yang terkontrol. Alat ini dilengkapi dengan pengatur suhu dan pengatur waktu. Kisaran suhu untuk inkubator produksi Heraeus B5042 misalnya adalah 10-70oC.
Dari uraian tersebut,tersirat bahwa nama pada setiap alat menggambarkan mengenai kegunaan alat dan atau menggambarkan prinsip kerja pada alat yang bersangkutan. Dalam penggunaannya ada alat-alat yang bersifat umum dan ada pula yang khusus. Peralatan umum biasanya digunakan untuk suatu kegiatan reparasi, sedangkan peralatan khusus lebih banyak digunakan untuk suatu pengukuran atau penentuan (Moningka,2008).
Antonie Van Leuwenhook adalah orang yang pertama kali melihat bakteri dengan menggunakan instrumen optik yang terdiri atas lensa bikonvens. Pada waktu itu ia menemukan bakteri dalam berbagai cairan, diantara cairan tubuh, air, ekstrak lada, serta bir. Penemuan mikroskop pada waktu itu membuka peluang unttuk dilakukannya penelitian mengenai proses terjadinya fermentasi dan penemuan jasad renik penyebab penyakit (Ferdias, 1992).
Mikroskop adalah alat yang paling khas dalam laboratorium mikrobiologi yang memberikan perbesaran yang membuat kita dapat melihat struktur mikroorganisme yang tidak dapat dilihat oleh mata telanjang. Mikroskop yang tersedia menungkinkan jangkauan perbesaran yang luas dari beberapa kali hingga ribuan kali (Lay,1994).
Adapun alat-alat yang dipergunakan pada laboratorium mikrobiologi antara lain (Blacksweetranger,2008) :
• Mikroskop Cahaya (Brightfield Microscope)
Salah satu alat untuk melihat sel mikroorganisme adalah mikroskop cahaya. Dengan mikroskop kita dapat mengamati sel bakteri yang tidak dapat dilihat dengan mata telanjang. Pada umumnya mata tidak mampu membedakan benda dengan diameter lebih kecil dari 0,1 mm. berikut merupakan uraian tentang cara penggunaan bagian-bagiandan spesifikasi mikroskop cahaya merk Olympus CH20 yang dimiliki Laboratorium Mikrobiologi.
• Autoklaf
Autoklaf adalah alat untuk mensterilkan berbagai macam alat dan bahan yang digunakan dalam mikrobiologi menggunakan uap air panas bertekanan. Tekanan yang digunakan pada umumnya 15 Psi atau sekitar 2 atm dan dengan suhu 121oC (250oF). Jadi tekanan yang bekerja ke seluruh permukaan benda adalah 15 pon tiap inchi2 (15 Psi = 15 pounds per square inch). Lama sterilisasi yang dilakukan biasanya 15 menit untuk 121oC.
• Inkubator (Incubator)
Inkubator adalah alat untuk menginkubasi atau memeram mikroba pada suhu yang terkontrol. Alat ini dilengkapi dengan pengatur suhu dan pengatur waktu. Kisaran suhu untuk inkubator produksi Heraeus B5042 misalnya adalah 10-70oC.
• Hot plate stirrer dan Stirrer bar
Hot plate stirrer dan Stirrer bar (magnetic stirrer) berfungsi untuk menghomogenkan suatu larutan dengan pengadukan. Pelat (plate) yang terdapat dalam alat ini dapat dipanaskan sehingga mampu mempercepat proses homogenisasi. Pengadukan dengan bantuan batang magnet Hot plate dan magnetic stirrer seri SBS-100 dari SBS® misalnya mampu menghomogenkan sampai 10 L, dengan kecepatan sangat lambat sampai 1600 rpm dan dapat dipanaskan sampai 425oC.
• Colony counter
Alat ini berguna untuk mempermudah perhitungan koloni yang tumbuh setelah diinkubasi di dalam cawankarena adanya kaca pembesar. Selain itu alat tersebut dilengkapi dengan skala/ kuadran yang sangat berguna untuk pengamatan pertumbuhan koloni sangat banyak. Jumlah koloni pada cawan Petri dapat ditandai dan dihitung otomatis yang dapat di-reset.
• Biological Safety Cabinet
Biological Safety Cabinet (BSC) atau dapat juga disebut Laminar Air Flow (LAF) adalah alat yang berguna untuk bekerja secara aseptis karena BSC mempunyai pola pengaturan dan penyaring aliran udara sehingga menjadi steril dan aplikasisinar UV beberapa jam sebelum digunakan.
• Mikropipet (Micropippete) dan Tip
Mikropipet adalah alat untuk memindahkan cairan yang bervolume cukup kecil, biasanya kurang dari 1000 µl. Banyak pilihan kapasitas dalam mikropipet, misalnya mikropipet yang dapat diatur volume pengambilannya (adjustable volume pipette) antara 1µl sampai 20 µl, atau mikropipet yang tidak bisa diatur volumenya, hanya tersedia satu pilihan volume (fixed volume pipette) misalnya mikropipet 5 µl. dalam penggunaannya, mukropipet memerlukan tip.
• Cawan Petri (Petri Dish)
Cawan petri berfungsi untuk membiakkan (kultivasi) mikroorganisme. Medium dapat dituang ke cawan bagian bawah dan cawan bagian atas sebagai penutup. Cawan petri tersedia dalam berbagai macam ukuran, diameter cawan yang biasa berdiameter 15 cm dapat menampung media sebanyak 15-20 ml, sedangkan cawan berdiameter 9 cm kira-kira cukup diisi media sebanyak 10 ml.
• Tabung reaksi (Reaction Tube / Test Tube)
Di dalam mikrobiologi, tabung reaksi digunakan untuk uji-uji biokimiawi dan menumbuhkan mikroba.Tabung reaksi dapat diisi media padat maupun cair. Tutup tabung reaksi dapat berupa kapas, tutup metal, tutup plastik atau aluminium foil. Media padat yang dimasukkan ke tabung reaksi dapat diatur menjadi 2 bentuk menurut fungsinya, yaitu media agar tegak (deep tube agar) dan agar miring (slants agar). Untuk membuat agar miring, perlu diperhatikan tentang kemiringan media yaitu luas permukaan yang kontak dengan udara tidak terlalu sempit atau tidak terlalu lebar dan hindari jarak media yang terlalu dekat dengan mulut tabung karena memperbesar resiko kontaminasi. Untuk alasan efisiensi, media yang ditambahkan berkisar 10-12 ml tiap tabung.
Hot plate stirrer dan Stirrer bar (magnetic stirrer) berfungsi untuk menghomogenkan suatu larutan dengan pengadukan. Pelat (plate) yang terdapat dalam alat ini dapat dipanaskan sehingga mampu mempercepat proses homogenisasi. Pengadukan dengan bantuan batang magnet Hot plate dan magnetic stirrer seri SBS-100 dari SBS® misalnya mampu menghomogenkan sampai 10 L, dengan kecepatan sangat lambat sampai 1600 rpm dan dapat dipanaskan sampai 425oC.
• Colony counter
Alat ini berguna untuk mempermudah perhitungan koloni yang tumbuh setelah diinkubasi di dalam cawankarena adanya kaca pembesar. Selain itu alat tersebut dilengkapi dengan skala/ kuadran yang sangat berguna untuk pengamatan pertumbuhan koloni sangat banyak. Jumlah koloni pada cawan Petri dapat ditandai dan dihitung otomatis yang dapat di-reset.
• Biological Safety Cabinet
Biological Safety Cabinet (BSC) atau dapat juga disebut Laminar Air Flow (LAF) adalah alat yang berguna untuk bekerja secara aseptis karena BSC mempunyai pola pengaturan dan penyaring aliran udara sehingga menjadi steril dan aplikasisinar UV beberapa jam sebelum digunakan.
• Mikropipet (Micropippete) dan Tip
Mikropipet adalah alat untuk memindahkan cairan yang bervolume cukup kecil, biasanya kurang dari 1000 µl. Banyak pilihan kapasitas dalam mikropipet, misalnya mikropipet yang dapat diatur volume pengambilannya (adjustable volume pipette) antara 1µl sampai 20 µl, atau mikropipet yang tidak bisa diatur volumenya, hanya tersedia satu pilihan volume (fixed volume pipette) misalnya mikropipet 5 µl. dalam penggunaannya, mukropipet memerlukan tip.
• Cawan Petri (Petri Dish)
Cawan petri berfungsi untuk membiakkan (kultivasi) mikroorganisme. Medium dapat dituang ke cawan bagian bawah dan cawan bagian atas sebagai penutup. Cawan petri tersedia dalam berbagai macam ukuran, diameter cawan yang biasa berdiameter 15 cm dapat menampung media sebanyak 15-20 ml, sedangkan cawan berdiameter 9 cm kira-kira cukup diisi media sebanyak 10 ml.
• Tabung reaksi (Reaction Tube / Test Tube)
Di dalam mikrobiologi, tabung reaksi digunakan untuk uji-uji biokimiawi dan menumbuhkan mikroba.Tabung reaksi dapat diisi media padat maupun cair. Tutup tabung reaksi dapat berupa kapas, tutup metal, tutup plastik atau aluminium foil. Media padat yang dimasukkan ke tabung reaksi dapat diatur menjadi 2 bentuk menurut fungsinya, yaitu media agar tegak (deep tube agar) dan agar miring (slants agar). Untuk membuat agar miring, perlu diperhatikan tentang kemiringan media yaitu luas permukaan yang kontak dengan udara tidak terlalu sempit atau tidak terlalu lebar dan hindari jarak media yang terlalu dekat dengan mulut tabung karena memperbesar resiko kontaminasi. Untuk alasan efisiensi, media yang ditambahkan berkisar 10-12 ml tiap tabung.
• Labu Erlenmeyer (Erlenmeyer Flask)
Berfungsi untuk menampung larutan, bahan atau cairan yang. Labu Erlenmeyer dapat digunakan untuk meracik dan menghomogenkan bahan-bahan komposisi media, menampung akuades, kultivasi mikroba dalam kultur cair, dll. Terdapat beberapa pilihan berdasarkan volume cairan yang dapat ditampungnya yaitu 25 ml, 50 ml, 100 ml, 250 ml, 300 ml, 500 ml, 1000 ml, dsb.
• Gelas ukur (Graduated Cylinder)
Berguna untuk mengukur volume suatu cairan, seperti labu erlenmeyer, gelas ukur memiliki beberapa pilihan berdasarkan skala volumenya. Pada saat mengukur volume larutan, sebaiknya volume tersebut ditentukan berdasarkan meniskus cekung larutan.
Berfungsi untuk menampung larutan, bahan atau cairan yang. Labu Erlenmeyer dapat digunakan untuk meracik dan menghomogenkan bahan-bahan komposisi media, menampung akuades, kultivasi mikroba dalam kultur cair, dll. Terdapat beberapa pilihan berdasarkan volume cairan yang dapat ditampungnya yaitu 25 ml, 50 ml, 100 ml, 250 ml, 300 ml, 500 ml, 1000 ml, dsb.
• Gelas ukur (Graduated Cylinder)
Berguna untuk mengukur volume suatu cairan, seperti labu erlenmeyer, gelas ukur memiliki beberapa pilihan berdasarkan skala volumenya. Pada saat mengukur volume larutan, sebaiknya volume tersebut ditentukan berdasarkan meniskus cekung larutan.
• Tabung Durham
Tabung durham berbentuk mirip dengan tabung reaksi namun ukurannya lebih kecil dan berfungsi untuk menampung/menjebak gas yang terbentuk akibat metabolisme pada bakteri yang diujikan. Penempatannya terbalik dalam tabung reaksi dan harus terendam sempurna dalam media (jangan sampai ada sisa udara).
• Jarum Inokulum
Jarum inokulum berfungsi untuk memindahkan biakan untuk ditanam/ditumbuhkan ke media baru. Jarum inokulum biasanya terbuat dari kawat nichrome atau platinum sehingga dapat berpijar jika terkena panas. Bentuk ujung jarum dapat berbentuk lingkaran (loop) dan disebut ose atau inoculating loop/transfer loop, dan yang berbentuk lurus disebut inoculating needle/Transfer needle. Inoculating loop cocok untuk melakukan streak di permukaan agar, sedangkan inoculating needle cocok digunakan untuk inokulasi secara tusukan pada agar tegak (stab inoculating).
Pada prinsipnya sterilisasi dapat dilakukan dengan 3 cara yaitu secara mekanik, fisik dan kimiawi (Indra, 2008) :
1. Sterilisai secara mekanik (filtrasi) menggunakan suatu saringan yang berpori sangat kecil (0.22 mikron atau 0.45 mikron) sehingga mikroba tertahan pada saringan tersebut. Proses ini ditujukan untuk sterilisasi bahan yang peka panas, misal nya larutan enzim dan antibiotik.
2. Sterilisasi secara fisik dapat dilakukan dengan pemanasan & penyinaran.
• Pemanasan
a. Pemijaran (dengan api langsung): membakar alat pada api secara langsung, contoh alat : jarum inokulum, pinset, batang L, dll.
b. Panas kering: sterilisasi dengan oven kira-kira 60-1800C. Sterilisasi panas kering cocok untuk alat yang terbuat dari kaca misalnya erlenmeyer, tabung reaksi dll.
c. Uap air panas: konsep ini mirip dengan mengukus. Bahan yang mengandung air lebih tepat menggungakan metode ini supaya tidak terjadi dehidrasi.
d. Uap air panas bertekanan : menggunalkan autoklaf.
• Penyinaran dengan UV
Sinar Ultra Violet juga dapat digunakan untuk proses sterilisasi, misalnya untuk membunuh mikroba yang menempel pada permukaan interior Safety Cabinet dengan disinari lampu UV
3. Sterilisaisi secara kimiawi biasanya menggunakan senyawa desinfektan antara lain alkohol.
Tabung durham berbentuk mirip dengan tabung reaksi namun ukurannya lebih kecil dan berfungsi untuk menampung/menjebak gas yang terbentuk akibat metabolisme pada bakteri yang diujikan. Penempatannya terbalik dalam tabung reaksi dan harus terendam sempurna dalam media (jangan sampai ada sisa udara).
• Jarum Inokulum
Jarum inokulum berfungsi untuk memindahkan biakan untuk ditanam/ditumbuhkan ke media baru. Jarum inokulum biasanya terbuat dari kawat nichrome atau platinum sehingga dapat berpijar jika terkena panas. Bentuk ujung jarum dapat berbentuk lingkaran (loop) dan disebut ose atau inoculating loop/transfer loop, dan yang berbentuk lurus disebut inoculating needle/Transfer needle. Inoculating loop cocok untuk melakukan streak di permukaan agar, sedangkan inoculating needle cocok digunakan untuk inokulasi secara tusukan pada agar tegak (stab inoculating).
Pada prinsipnya sterilisasi dapat dilakukan dengan 3 cara yaitu secara mekanik, fisik dan kimiawi (Indra, 2008) :
1. Sterilisai secara mekanik (filtrasi) menggunakan suatu saringan yang berpori sangat kecil (0.22 mikron atau 0.45 mikron) sehingga mikroba tertahan pada saringan tersebut. Proses ini ditujukan untuk sterilisasi bahan yang peka panas, misal nya larutan enzim dan antibiotik.
2. Sterilisasi secara fisik dapat dilakukan dengan pemanasan & penyinaran.
• Pemanasan
a. Pemijaran (dengan api langsung): membakar alat pada api secara langsung, contoh alat : jarum inokulum, pinset, batang L, dll.
b. Panas kering: sterilisasi dengan oven kira-kira 60-1800C. Sterilisasi panas kering cocok untuk alat yang terbuat dari kaca misalnya erlenmeyer, tabung reaksi dll.
c. Uap air panas: konsep ini mirip dengan mengukus. Bahan yang mengandung air lebih tepat menggungakan metode ini supaya tidak terjadi dehidrasi.
d. Uap air panas bertekanan : menggunalkan autoklaf.
• Penyinaran dengan UV
Sinar Ultra Violet juga dapat digunakan untuk proses sterilisasi, misalnya untuk membunuh mikroba yang menempel pada permukaan interior Safety Cabinet dengan disinari lampu UV
3. Sterilisaisi secara kimiawi biasanya menggunakan senyawa desinfektan antara lain alkohol.
DAFTAR PUSTAKA
Blacksweetheart., 2008 , http:/wordpress.com/Pengenalan- alat/Blacksweetranger’s /Blog.htm .diakses pada tanggal 08 maret 2009, Makassar.
Ferdias, S., 1992, Mikrobiologi Pangan, Gramedia Pustaka Utama, Jakarta.
Indra., 2008, http//ekmon-saurus/bab-3-Sterilisasi/.htm . diakses pada tanggal 08 maret 2009, Makassar.
Lay, B., 1994, Analisis Mikroba di Laboratorium, Raja Grafindo Persada, Jakarta.
Moningka, Harvey., 2008, http://harveymoningka.wordpress.com/teknik- laboratorium- pengenalan-alat-dan-bahan/trackback/.diakses pada tanggal 08 maret 2009, Makassar.
Blacksweetheart., 2008 , http:/wordpress.com/Pengenalan- alat/Blacksweetranger’s /Blog.htm .diakses pada tanggal 08 maret 2009, Makassar.
Ferdias, S., 1992, Mikrobiologi Pangan, Gramedia Pustaka Utama, Jakarta.
Indra., 2008, http//ekmon-saurus/bab-3-Sterilisasi/.htm . diakses pada tanggal 08 maret 2009, Makassar.
Lay, B., 1994, Analisis Mikroba di Laboratorium, Raja Grafindo Persada, Jakarta.
Moningka, Harvey., 2008, http://harveymoningka.wordpress.com/teknik- laboratorium- pengenalan-alat-dan-bahan/trackback/.diakses pada tanggal 08 maret 2009, Makassar.
Mikroskop Cahaya (Brightfield Microscope)
Salah satu alat untuk melihat sel mikroorganisme adalah mikroskop cahaya. Dengan mikroskop kita dapat mengamati sel bakteri yang tidak dapat dilihat dengan mata telanjang. Pada umumnya mata tidak mampu membedakan benda dengan diameter lebih kecil dari 0,1 mm. berikut merupakan uraian tentang cara penggunaan bagian-bagiandan spesifikasi mikroskop cahaya merk Olympus CH20 yang dimiliki Laboratorium Mikrobiologi.Bagian-bagian Mikroskop:
- Eyepiece / oculars (lensa okuler)
Untuk memperbesar bayangan yang dibentuk lensa objektif
- Revolving nosepiece (pemutar lensa objektif)
Untuk memutar objektif sehingga mengubah perbesaran
- Observation tube (tabung pengamatan / tabung okuler)
- Stage (meja benda)
Spesimen diletakkan di sini
- Condenser (condenser)
Untuk mengumpulkan cahaya supaya tertuju ke lensa objektif
- Objective lense (lensa objektif)
Memperbesar spesimen
- Brightness adjustment knob (pengatur kekuatan lampu)
Untuk memperbesar dan memperkecil cahaya lampu
- Main switch (tombol on-off)
- Diopter adjustmet ring (cincin pengatur diopter)
Untuk menyamakan focus antara mata kanan dan kiri
- Interpupillar distance adjustment knob (pengatur jarak interpupillar)
- Specimen holder (penjepit spesimen)
- Illuminator (sumber cahaya)
- Vertical feed knob (sekrup pengatur vertikal)
Untuk menaikkan atau menurunkan object glass
- Horizontal feed knob (sekrup pengatur horizontal)
Untuk menggeser ke kanan / kiri objek glas
- Coarse focus knob (sekrup fokus kasar)
Menaik turunkan meja benda (untuk mencari fokus) secara kasar dan cepat
- Fine focus knob (sekrup fokus halus)
Menaik turunkan meja benda secara halus dan lambat
- Observation tube securing knob (sekrup pengencang tabung okuler)
- Condenser adjustment knob (sekrup pengatur kondenser)
Untuk menaik-turunkan kondenser
Prosedur Operasi
1. Menyalakan lampu
a. tekan tombol on (8)
b. atur kekuatan lampu dengan memutar bagian (7)
2. Menempatkan spesimen pada meja benda
a. Letakan objek glas diatas meja benda (4) kemudian jepit dengan (11). Jika meja benda belum turun, diturunkan dengan sekrup kasar (15)
b.Cari bagian dari objek glas yang terdapat preparat ulas (dicari dan diperkirakan memiliki gambar yang jelas) dengan memutar sekrup vertikal dan horizontal (13) dan (14)
3. Memfokuskan
a. Putar Revolving nosepiece (2) pada perbesaran objektif 4x lalu putar sekrup kasar (15) sehingga meja benda bergerak ke atas untuk mencari fokus
b.Setelah fokus perbesaran 4 x 10 didapatkan, maka putar (2) pada perbesaran selanjutnya yaitu perbesaran objektif 10x. kemudian putar sekrup halus (16) untuk mendapatkan fokusnya
c. Lakukan hal yang sama jika menggunakan perbesaran yang lebih tinggi
Berikut adalah tabel yang menunjukan jarak antara spesimen dengan lensa objektif jika okus telah didapatkan
Catatan: Setelah mendapatkkan fokus pada perbesaran tetentu, misal 40x, dan ingin memutar objektif ke perbesaran 100x, maka meja benda tidak perlu diturunkan dan tidak perlu khawatir bahwa lensa objektif akan menggesek cover glass karena terdapat sisa jarak A yang lebih kecil antara cover glass dengan lensa objektif (lihat tabel diatas).
4. Tambahan
a. Jika perlu interpupillar distance adjustment knob (10) dapat digeser, hal ini akan mengubah dua bayangan yang akan diterima oleh 2 mata menjadi gambar yang tunggal sehingga sangat membantu dalam mengatasi kelelahan mata
b. Jika perlu diopter adjustment knob (9) dapat diatur untuk memperoleh bayangan focus yang seimbang antara mata kanan dan kiri
c. Pengaturan condenser (5) akan memperjelas bayangan yang tampak dengan mensetting pada posisi tertinggi (cahaya penuh)
Perbesaran total
Ukuran specimen yang diamati dapat diperoleh dengan mengalikan perbesaran lensa okuler dengan lensa objektif. Misal = Okuler (10x) x Objektif (40x) = 400x
Penggunaan minyak imersi
Semakin kecil nilai daya pisah, akan semakin kuat kemampuan lensa untuk memisahkan dua titikyang berdekatan pada preparat sehingga struktur benda terlihat lebih jelas. Daya pisah dapat diperkuat dengan memperbesarkan indeks bias atau menggunakan cahaya yang memiliki panjang gelombang (λ) pendek. Biasanya dapat digunakan minyak imersi untuk meningkatkan indeks bias pada perbesaran 10 x 100
a. Jika fokus pada perbesaran 10 x 40 telah didapatkan maka putar ke perbesaran objektif 100x
b. tetesi minyak imersi 1 – 2 tetes dari sisi lensa
c. Jika telah selesai menggunakan mikroskop, bersihkan lensa objektif 100x dengan kertas lensa yang dibasahi xylol
Mikroskop stereo (Zoom Stereo Microscope)
Mikroskop ini berfungsi untuk melihat objek yang membutuhkan perbesaran tidak terlalu besar. Di Laboratorium Mikrobiologi, mikroskop stereo biasanya digunakan untuk mengamati secara detail bentuk koloni dan jamur. Berikut merupakan uraian tentang mikroskop stereo yang dimiliki Laboratorium Mikrobiologi yaitu Zoom Stereo Microscope, Olimpus SZ3060.
1. Oculars eyepiece (lensa okuler)
2. Diopter adjustment ring (cincin pengatur diopter)
3. Zoom control knob (sekrup pengatur pembesaran)
4. Focusing knob (sekrup pengatur fokus)
5. Stage plate (pelat tempat specimen diletakkan)
6. Stage clip (penjepit spesimen / preparat)
Prosedur operasi
- Letakkan spesimen / preparat di stage plate (5), jepit jika perlu
- Atur perbesaran pada perbesaran terkecil dengan memutar Zoom Control Knob (3) kemudian dicari fokusnya dengan memutar Focusing Knob (4)
- Jika ingin mendapatkan bayangan yang lebih besar, putar Zoom Control Knob (3) ke perbesaran yang lebih tinggi kemudian dicari fokusnya
Mikroskop ini memiliki pilihan perbesaran:
Autoklaf (Autoclave)
Diagram autoklaf vertical
1. Tombol pengatur waktu mundur (timer)
2. Katup pengeluaran uap
3. pengukur tekanan
4. kelep pengaman
5. Tombol on-off
6. Termometer
7. Lempeng sumber panas
8. Aquades (dH2O)
9. Sekrup pengaman
10. batas penambahan air
Autoclave adalah alat untuk mensterilkan berbagai macam alat dan bahan yang digunakan dalam mikrobiologi menggunakan uap air panas bertekanan. Tekanan yang digunakan pada umumnya 15 Psi atau sekitar 2 atm dan dengan suhu 121oC (250oF). Jadi tekanan yang bekerja ke seluruh permukaan benda adalah 15 pon tiap inchi2 (15 Psi = 15 pounds per square inch). Lama sterilisasi yang dilakukan biasanya 15 menit untuk 121oC.
Cara Penggunaan :
1. Sebelum melakukan sterilisasi cek dahulu banyaknya air dalam autoklaf. Jika air kurang dari batas yang ditentukan, maka dapat ditambah air sampai batas tersebut. Gunakan air hasil destilasi, untuk menghindari terbentuknya kerak dan karat.
2. Masukkan peralatan dan bahan. Jika mensterilisasi botol beretutup ulir, maka tutup harus dikendorkan.
3. Tutup autoklaf dengan rapat lalu kencangkan baut pengaman agar tidak ada uap yang keluar dari bibir autoklaf. Klep pengaman jangan dikencangkan terlebih dahulu.
4. Nyalakan autoklaf, diatur timer dengan waktu minimal 15 menit pada suhu 121oC.
5. Tunggu samapai air mendidih sehingga uapnya memenuhi kompartemen autoklaf dan terdesak keluar dari klep pengaman. Kemudian klep pengaman ditutup (dikencangkan) dan tunggu sampai selesai. Penghitungan waktu 15’ dimulai sejak tekanan mencapai 2 atm.
6. Jika alarm tanda selesai berbunyi, maka tunggu tekanan dalam kompartemen turun hingga sama dengan tekanan udara di lingkungan (jarum pada preisure gauge menunjuk ke angka nol). Kemudian klep-klep pengaman dibuka dan keluarkan isi autoklaf dengan hati-hati.
Inkubator (Incubator)
Inkubator adalah alat untuk menginkubasi atau memeram mikroba pada suhu yang terkontrol. Alat ini dilengkapi dengan pengatur suhu dan pengatur waktu. Kisaran suhu untuk inkubator produksi Heraeus B5042 misalnya adalah 10-70oC..
· Hot plate stirrer dan Stirrer bar
Hot plate stirrer dan Stirrer bar (magnetic stirrer) berfungsi untuk menghomogenkan suatu larutan dengan pengadukan. Pelat (plate) yang terdapat dalam alat ini dapat dipanaskan sehingga mampu mempercepat proses homogenisasi. Pengadukan dengan bantuan batang magnet Hot plate dan magnetic stirrer seri SBS-100 dari SBS® misalnya mampu menghomogenkan sampai 10 L, dengan kecepatan sangat lambat sampai 1600 rpm dan dapat dipanaskan sampai 425oC
· Colony counter
Alat ini berguna untuk mempermudah perhitungan koloni yang tumbuh setelah diinkubasi di dalam cawankarena adanya kaca pembesar. Selain itu alat tersebut dilengkapi dengan skala/ kuadran yang sangat berguna untuk pengamatan pertumbuhan koloni sangat banyak. Jumlah koloni pada cawan Petri dapat ditandai dan dihitung otomatis yang dapat di-reset.
· Biological Safety Cabinet
Biological Safety Cabinet (BSC) atau dapat juga disebut Laminar Air Flow (LAF) adalah alat yang berguna untuk bekerja secara aseptis karena BSC mempunyai pola pengaturan dan penyaring aliran udara sehingga menjadi steril dan aplikasisinar UV beberapa jam sebelum digunakan. Prosedur penggunaan BSC seri 36212, Purifier™ Biological Safety Cabinet dari LABCONCO yang dimiliki laboratorium mikrobiologi adalah sebagai berikut:
1. Hidupkan lampu UV selama 2 jam, selanjutnya matikan segera sebelum mulai bekerja
2. Pastikan kaca penutup terkunci dan pada posisi terendah
3. Nyalakan lampu neon dan blower
4. Biarkan selama 5 menit
5. Cuci tangan dan lengan dengan sabun gemisidal / alkohol 70 %
6. Usap permukaan interior BSC dengan alkohol 70 % atau desinfektan yang cocok dan biarkan menguap
7. masukkan alat dan bahan yang akan dikerjakan, jangan terlalu penuh (overload) karena memperbesar resiko kontaminan
8. Atur alat dan bahan yang telah dimasukan ke BSC sedemikian rupa sehingga efektif dalam bekerja dan tercipta areal yang benar-benar steril
9. Jangan menggunakan pembakar Bunsen dengan bahan bakar alkohol tapi gunakan yang berbahan bakar gas.
10. Kerja secara aseptis dan jangan sampai pola aliran udara terganggu oleh aktivitas kerja
11. setelah selesai bekerja, biarkan 2-3 menit supaya kontaminan tidak keluar dari BSC
12. Usap permukaan interior BSC dengan alkohol 70 % dan biarkan menguap lalu tangan dibasuh dengan desinfektan
13. Matikan lampu neon dan blower
· Mikropipet (Micropippete) dan Tip
Mikropipet adalah alat untuk memindahkan cairan yang bervolume cukup kecil, biasanya kurang dari 1000 µl. Banyak pilihan kapasitas dalam mikropipet, misalnya mikropipet yang dapat diatur volume pengambilannya (adjustable volume pipette) antara 1µl sampai 20 µl, atau mikropipet yang tidak bisa diatur volumenya, hanya tersedia satu pilihan volume (fixed volume pipette) misalnya mikropipet 5 µl. dalam penggunaannya, mukropipet memerlukan tip.
Cara Penggunaan :
1. Sebelum digunakan Thumb Knob sebaiknya ditekan berkali-kali untuk memastikan lancarnya mikropipet.
2. Masukkan Tip bersih ke dalam Nozzle / ujung mikropipet.
3. Tekan Thumb Knob sampai hambatan pertama / first stop, jangan ditekan lebih ke dalam lagi.
4. Masukkan tip ke dalam cairan sedalam 3-4 mm.
5. Tahan pipet dalam posisi vertikal kemudian lepaskan tekanan dari Thumb Knob maka cairan akan masuk ke tip.
6. Pindahkan ujung tip ke tempat penampung yang diinginkan.
7. Tekan Thumb Knob sampai hambatan kedua / second stop atau tekan semaksimal mungkin maka semua cairan akan keluar dari ujung tip.
8. Jika ingin melepas tip putar Thumb Knob searah jarum jam dan ditekan maka tip akan terdorong keluar dengan sendirinya, atau menggunakan alat tambahan yang berfungsi mendorong tip keluar.
Cawan Petri (Petri Dish)
Cawan petri berfungsi untuk membiakkan (kultivasi) mikroorganisme. Medium dapat dituang ke cawan bagian bawah dan cawan bagian atas sebagai penutup. Cawan petri tersedia dalam berbagai macam ukuran, diameter cawan yang biasa berdiameter 15 cm dapat menampung media sebanyak 15-20 ml, sedangkan cawan berdiameter 9 cm kira-kira cukup diisi media sebanyak 10 ml.
· Pipet Ukur (Measuring Pippete)
Pipet ukur merupakan alat untuk memindahkan larutan dengan volume yang diketahui. Tersedia berbagai macam ukuran kapasitas pipet ukur, diantaranya pipet berukuran 1 ml, 5 ml dan 10 ml. Cara penggunaanya adalah cairan disedot dengan pipet ukur dengan bantuan filler sampai dengan volume yang diingini. Volume yang dipindahkan dikeluarkan menikuti skala yang tersedia (dilihat bahwa skala harus tepat sejajar dengan mensikus cekung cairan) dengan cara menyamakan tekanan filler dengan udara sekitar
Pipet tetes (Pasteur Pippete)
Fungsinya sama dengan pipet ukur, namun volume yang dipindahkan tidak diketahui. Salah satu penerapannya adalah dalam menambahkan HCl / NaOH saat mengatur pH media, penambahan reagen ada uji biokimia, dll.
· Tabung reaksi (Reaction Tube / Test Tube)
Di dalam mikrobiologi, tabung reaksi digunakan untuk uji-uji biokimiawi dan menumbuhkan mikroba.Tabung reaksi dapat diisi media padat maupun cair. Tutup tabung reaksi dapat berupa kapas, tutup metal, tutup plastik atau aluminium foil. Media padat yang dimasukkan ke tabung reaksi dapat diatur menjadi 2 bentuk menurut fungsinya, yaitu media agar tegak (deep tube agar) dan agar miring (slants agar). Untuk membuat agar miring, perlu diperhatikan tentang kemiringan media yaitu luas permukaan yang kontak dengan udara tidak terlalu sempit atau tidak terlalu lebar dan hindari jarak media yang terlalu dekat dengan mulut tabung karena memperbesar resiko kontaminasi. Untuk alas an efisiensi, media yang ditambahkan berkisar 10-12 ml tiap tabung
· Labu Erlenmeyer (Erlenmeyer Flask)
Berfungsi untuk menampung larutan, bahan atau cairan yang. Labu Erlenmeyer dapat digunakan untuk meracik dan menghomogenkan bahan-bahan komposisi media, menampung akuades, kultivasi mikroba dalam kultur cair, dll. Terdapat beberapa pilihan berdasarkan volume cairan yang dapat ditampungnya yaitu 25 ml, 50 ml, 100 ml, 250 ml, 300 ml, 500 ml, 1000 ml, dsb· Gelas ukur (Graduated Cylinder)
Berguna untuk mengukur volume suatu cairan, seperti labu erlenmeyer, gelas ukur memiliki beberapa pilihan berdasarkan skala volumenya. Pada saat mengukur volume larutan, sebaiknya volume tersebut ditentukan berdasarkan meniskus cekung larutan.
Batang L (L Rod)
Batang L bermanfaat untuk menyebarkan cairan di permukaan agar supaya bakteri yang tersuspensi dalam cairan tersebut tersebar merata. Alat ini juga disebut spreaderMortar dan Pestle
Mortar dan penumbuk (pastle) digunakan untuk menumbuk atau menghancurkan materi cuplikan, misal daging, roti atau tanah sebelum diproses lebih lanjutBeaker Glass
Beaker glass merupakan alat yang memiliki banyak fungsi. Di dalam mikrobiologi, dapat digunakan untuk preparasi media media, menampung akuades dll.Pembakar Bunsen (Bunsen Burner)
Salah satu alat yang berfungsi untuk menciptakan kondisi yang steril adalah pembakar bunsen. Untuk sterilisasi jarum ose atau yang lain, bagian api yang paling cocok untuk memijarkannya adalah bagian api yang berwarna biru (paling panas). Perubahan bunsen dapat menggunakan bahan bakar gas atau metanolGlass Beads
Glass Beads adalah manik-manik gelas kecil yang digunakan untuk meratakan suspensi biakan dengan menyebarkan beberapa butir di atas permukaan agar dan digoyang merata. Glass beads digunakan pada teknik spread plate yang fungsinya sama dengan batang L atau Spreader.
· Tabung Durham
Tabung durham berbentuk mirip dengan tabung reaksi namun ukurannya lebih kecil dan berfungsi untuk menampung/menjebak gas yang terbentuk akibat metabolisme pada bakteri yang diujikan. Penempatannya terbalik dalam tabung reaksi dan harus terendam sempurna dalam media (jangan sampai ada sisa udara).Jarum Inokulum
Jarum inokulum berfungsi untuk memindahkan biakan untuk ditanam/ditumbuhkan ke media baru. Jarum inokulum biasanya terbuat dari kawat nichrome atau platinum sehingga dapat berpijar jika terkena panas. Bentuk ujung jarum dapat berbentuk lingkaran (loop) dan disebut ose atau inoculating loop/transfer loop, dan yang berbentuk lurus disebut inoculating needle/Transfer needle. Inoculating loop cocok untuk melakukan streak di permukaan agar, sedangkan inoculating needle cocok digunakan untuk inokulasi secara tusukan pada agar tegak (stab inoculating). Jarum inokulum ini akan sangat bermanfaat saat membelah agar untuk preprasi Heinrich’s Slide Culture.
Pinset
Pinset memiliki banyak fungsi diantaranya adalah untuk mengambil benda dengan menjepit misalnya saat memindahkan cakram antibiotikpH Indikator Universal
berguna untuk mengukur/mengetahui pH suatu larutan. Hal ini sangat penting dalam pembuatan media karena pH pada media berpengaruh terhadap petumbuhan mikroba. Kertas pH indikator dicelupkan sampai tidak ada perubahan warna kemudian strip warna dicocokkan dengan skala warna acuan.
Pipet Filler / Rubber Bulb
Filler adalah alat untuk menyedot larutan yang dapat dipasang pada pangkal pipet ukur. Karet sebagai bahan filler merupakan karet yang resisten bahan kimia. Fillermemiliki 3 saluran yang masing-masing saluran memiliki katup. Katup yang bersimbol A (aspirate) berguna untuk mengeluarkan udara dari gelembung. S (suction) merupakan katup yang jika ditekan maka cairan dari ujung pipet akan tersedot ke atas. Kemudian katup E (exhaust) berfungsi untuk mengeluarkan cairan dari pipet ukur.

Tidak ada komentar:
Posting Komentar